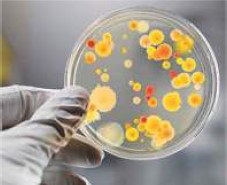
Enunciado 3502599-1

Foram encontradas 50 questões.
"Em janeiro deste ano, ao sobrevoarem o litoral do Estado do Espírito Santo e do sul da Bahia, biólogos, oceanógrafos e técnicos de órgãos ambientais do governo federal reconheceram os borrões escuros na superfície do mar formados pelo acúmulo de resíduos metálicos que vazaram do reservatório da mineradora Samarco em Mariana, Minas Gerais, em novembro de 2015. A mancha de resíduos, também chamada de pluma, aproximava-se do arquipélago de Abrolhos, uma das principais reservas de vida silvestre marinha da costa brasileira."
(Carlos Fioravanti. Impactos Visíveis no Mar. In: Pesquisa FAPESP, abril/2015, p. 43)

http://revistapesquisa.fapesp.br/2016/04/19/impactos-visiveis-no-mar/
A lama da tragédia de Mariana chegou ao mar (vide mapa). Diante dessa situação é correto afirmar que
Provas
"Em janeiro deste ano, ao sobrevoarem o litoral do Estado do Espírito Santo e do sul da Bahia, biólogos, oceanógrafos e técnicos de órgãos ambientais do governo federal reconheceram os borrões escuros na superfície do mar formados pelo acúmulo de resíduos metálicos que vazaram do reservatório da mineradora Samarco em Mariana, Minas Gerais, em novembro de 2015. A mancha de resíduos, também chamada de pluma, aproximava-se do arquipélago de Abrolhos, uma das principais reservas de vida silvestre marinha da costa brasileira."
(Carlos Fioravanti. Impactos Visíveis no Mar. In: Pesquisa FAPESP, abril/2015, p. 43)
Para chegar ao oceano Atlântico, a lama vazada da mineradora na tragédia de Mariana percorreu antes centenas de quilômetros e teve várias consequências. A principal é descrita corretamente da seguinte maneira:
Provas
Observe o mapa e os gráficos a seguir:

Segundo o que está representado, pode ser afirmado que
Provas
"Quase sempre visto como um desafio ao desenvolvimento econômico, o envelhecimento da população passou a ser encarado pela França, Holanda e pelo Japão, entre outros países, como uma oportunidade de crescimento e inovação. Essa mudança na forma de pensar o papel do idoso na sociedade e as iniciativas pautadas pelo novo conceito foram o tema central do seminário Economia da Longevidade: oportunidade de Crescimento, Inovação e Bem-estar (...)"
(Economia da Longevidade. In Revista Brasileiros, Set/2015, p. 63)
Tendo em vista a composição e a dinâmica demográfica brasileira, e a condição do idoso nessa composição e no conjunto social, é correto dizer que
Provas
Cama Hospitalar Fawler com Elevação de Leito Manual

• Sistema de elevação com manivela acoplada ao leito.
• Todas as manivelas possuem sistema de Rolamento e Mancal.
• Rodízios de 3" DIM, com freio de dupla ação em diagonal.
• Capacidade máxima: 110 kg
• Dimensões: 1960 x 880 mm
• Altura mínima: 450 mm
• Altura máxima: 800 mm
http://www.ortocuritiba.com.br/locacao-de-cama-hospitalar-fawler-manual-com-elevacao.html [Adaptado]
Provas
A placa de Petri é um recipiente cilíndrico, achatado, de vidro ou plástico, utilizado para cultura de micro-organismos e constituída por duas partes: uma base e uma tampa. Em laboratórios de microbiologia e rotinas de bacteriologia, as placas de Petri são usadas para a identificação de micro-organismos. Num ensaio técnico, um laboratorista incide um feixe de luz monocromática de comprimento de onda igual a 600nm que, propagando-se inicialmente no ar, incide sobre a base de uma placa de Petri, conforme esquematizado na figura abaixo. Determine o índice de refração (n) do material da placa de Petri em relação ao ar, o comprimento (λ) e a frequência (f) da onda incidente enquanto atravessa a base da placa.
www.blog.mcientifica.com.br
|
|
Provas
Quando necessário, adote os seguintes valores na resolução dos exercícios de Física:

Desde o aparecimento de sistemas artificiais de estimulação cardíaca, dotados de circuitos de sensibilidade (os marcapassos), tem-se observado sua relativa vulnerabilidade frente a interferências de diferentes naturezas, tanto em situações ambientais características do dia a dia do paciente portador de marcapasso, quanto em circunstâncias em que há a necessidade de submetê-lo a procedimentos terapêuticos envolvendo correntes elétricas, ondas eletromagnéticas ou radiações. Campos magnéticos da ordem de 17,5!$ μ !$T são encontrados em regiões próximas a condutores de altas correntes como, por exemplo, alarmes antirroubo, detectores de metais, linhas de transmissão etc e podem inibir o gerador de estímulos cardíacos, mudando consequentemente seu comportamento.

http://paginas.fe.up.pt/~mam/Linhas-01.pdf [Adaptado]
Determine até que distância aproximada, em metros, de uma linha de transmissão muito comprida (condutor retilíneo), percorrida por uma corrente contínua de 217A, a uma tensão de 400kV, o campo magnético produzido teria magnitude capaz de poder alterar o comportamento do gerador de estímulos cardíacos. Adote: μ0= 4.!$ π !$.10-7 T.m.A-1 .
Provas
Pesquisas odontológicas buscam por modalidades adjuvantes de tratamento antimicrobiano com menor possibilidade de efeitos colaterais para o indivíduo. Oscar Raab, em 1900, observou a morte de microorganismos quando expostos à luz solar e ao ar, na presença de certos corantes, o que seria o princípio de uma nova modalidade clínica conhecida como Terapia Fotodinâmica (TFD). A fotossensibilização depende do corante utilizado, da sua concentração, fluência e intensidade de potência do laser, e da espécie bacteriana envolvida. Para ativar as substâncias fotossensibilizadoras responsáveis pelo processo fotodinâmico, é necessário o uso de luz com frequência ressonante com o nível de absorção óptica da referida substância. Para o processo fotodinâmico, a luz ideal deve ter densidade de potência adequada e ser colimada. A alta colimação dos feixes laser somados às altas densidades de potência fazem desse o equipamento ideal para a ativação. Lasers sólidos tipo Nd:YAG têm sido empregados mais recentemente, mas ainda apresentam elevado custo. No entanto, empregando-se lasers Nd:YAG, associados a alguns dispositivos ópticos, obtêm-se feixes de laser na faixa de 200 a 2 000nm, o que atende boa parte dos agentes fotossensibilizadores do mercado.
https://www.metodista.br/revistas/revistas-unimep/index.php/FOL/ article/viewArticle/248 (adaptado) Acessado em: 27/03/2016
| Frequência (Hz) |
| Rádio!$ \le !$ 3 x 109 |
| 3 x 109 < Micro-ondas !$ \le !$ 3 x 1012 |
| 3 x 1012 < Infravermelho !$ \le !$ 4,3 x 1014 |
| 4,3 x 1014 < Visível !$ \le !$ 7,5 x 1014 |
| 7,5 x 1014 < Ultravioleta !$ \le !$ 3 x 1017 |
| 3 x 1017 < Raios-X !$ \le !$ 3 x 1019 |
| Raios Gama > 3 x 1019 |
http://www.if.ufrgs.br/oei/cgu/espec/intro.htm [Adaptado] Acessado em: 27/03/2016

http://www.medicompras.com/equipo-laseryag- nd-q-switched Acessado em: 27/03/2016
Considerando-se a faixa dos tipos de feixes de lasers obtidos empregando-se lasers sólidos Nd:YAG, concluímos que as frequências produzidas estão na região compreendida entre:
Provas
O Forno de Bier, um dos dispositivos mais antigos da termoterapia utilizados pela fisioterapia, é assim denominado em homenagem ao seu inventor Dr. August Bier. É um compartimento que se coloca por sobre a região a ser tratada, dentro do qual é gerado calor a partir de resistências elétricas. Consiste em uma peça confeccionada com flandre e madeira, em forma de semicilindro, aberto nas duas extremidades. Quando o paciente é introduzido no seu interior, cobre-se o equipamento com um cobertor de flanela, para que haja um mínimo de perda de calor do forno para o meio externo, através das aberturas existentes em suas extremidades. Uma faixa de aplicação confiável fica em torno de 45 a 60°C. Para que o efeito terapêutico seja atingido nos tecidos, é importante que o tempo de aplicação fique em torno de 20 a 30 minutos. Se em uma clínica de fisioterapia são realizadas 10 aplicações diárias, de 30 minutos cada uma, com o forno de Bier especificado ao lado em sua potência máxima, qual o custo mensal, em reais, para essa clínica, devido ao uso desse aparelho, considerando-se 21 dias úteis e o custo do kWh de R$ 0,20?
http://ucbweb.castelobranco.br/webcaf/arquivos/12851/4899/apostila_fisio terapia_geral.pdf. Acessado em: 27/03/2016 [Adaptado]

| DETALHES DO PRODUTO |
| FORNO DE BIER SANTA LUZIA - calor superficial que pode ser aplicado para tronco e membros, para lombalgias, relaxamento muscular e preparação para cinesioterapia - estrutura confeccionada em madeira revestida em material cerâmico composto por fibras de aramida e lã de rocha e borracha NBR isolante - externamente é revestido com chapa de alumínio - resistências internas de níquel cromo de alta durabilidade, protegidas com isolante térmico cerâmico - termostato para regulagem de temperatura - desligamento automático - potência máxima: 1500 W - dimensões: 57 x 65 x 41 - 3 meses de garantia |
http://www.cirurgicazonasul.com.br/forno-de-bier-com-termostato/ Acessado em: 27/03/2016
Provas
Suponha que nos Jogos Olímpicos de 2016 apenas um representante do Brasil faça parte do grupo de atletas que disputarão a final da prova de natação dos 100 metros livres. Considerando que todos os oito atletas participantes têm a mesma chance de vencer, a probabilidade de que o brasileiro receba uma das medalhas (ouro, prata ou bronze) é de:
Provas
Caderno Container
